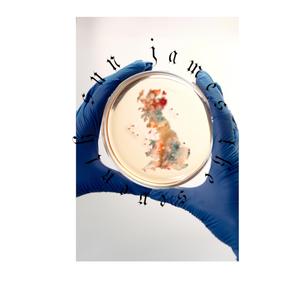
Brexit Behaviour

Blue House Walking
James the Seventh Sun

Croissant Acid Jam
James the Seventh Sun

Kid Valley 8
James the Seventh Sun

Big White House
James the Seventh Sun

Submarine
James the Seventh Sun

Unnatural Spaces (Head In The Clouds)
James the Seventh Sun
Brexit Behaviour
James the Seventh Sun

Denman Road
James the Seventh Sun

Violet Blue Dragon
James the Seventh Sun

Sun
アトラスサウンドチーム

Crumble
James the Seventh

Trauma Olympics
James the Seventh

Sun
Richard Sanderson

Sun
Steerner, Martell

SUN(太阳)
KKK, Mike

Mind Your Business
James the Seventh

Trauma Olympics (Demo Version)
James the Seventh

Trauma Olympics
James the Seventh

Shame
James the Seventh

Awkward
James the Seventh

Mind Your Business
James the Seventh

Mind Your Business
James the Seventh

Trauma Olympics
James the Seventh

Just Let Me Cry
James the Seventh

Turn a Blind Eye
James the Seventh

Up There
James the Seventh

When the Night Begins to Fall
James the Seventh

Unsexy
James the Seventh

You Don't Know Me
James the Seventh

Awkward
James the Seventh